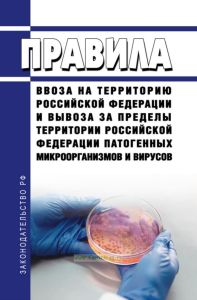
Правила ввоза на территорию Российской Федерации и вывоза за пределы территории Российской Федерации патогенных микроорганизмов и вирусов 2025 год. Последняя редакция

- Артикул:00-01043557
- ISBN: 978-5-901080-04-7
- Обложка: Мягкая обложка
- Издательство: ЦЕНТРМАГ (все книги издательства)
- Город: Москва
- Страниц: 8
- Формат: А5 (148x210 мм)
- Год: 2026
- Вес: 16 г
- Серия: Постановления Правительства РФ (все товары серии)
Документ продается с актуализацией на дату продажи!
Постановление Правительства РФ от 02.04.2022 N 572 "Об утверждении Правил ввоза на территорию Российской Федерации и вывоза за пределы территории Российской Федерации патогенных микроорганизмов и вирусов"
Настоящие Правила устанавливают порядок ввоза на территорию Российской Федерации и вывоза за пределы территории Российской Федерации патогенных микроорганизмов и вирусов, за исключением патогенных микроорганизмов и вирусов, подлежащих экспортному контролю согласно Списку микроорганизмов, токсинов, оборудования и технологий, подлежащих экспортному контролю, утвержденному Указом Президента Российской Федерации от 20 августа 2007 г. N 1083 "Об утверждении Списка микроорганизмов, токсинов, оборудования и технологий, подлежащих экспортному контролю", а также биологических материалов, полученных при проведении клинического исследования лекарственного препарата для медицинского применения.